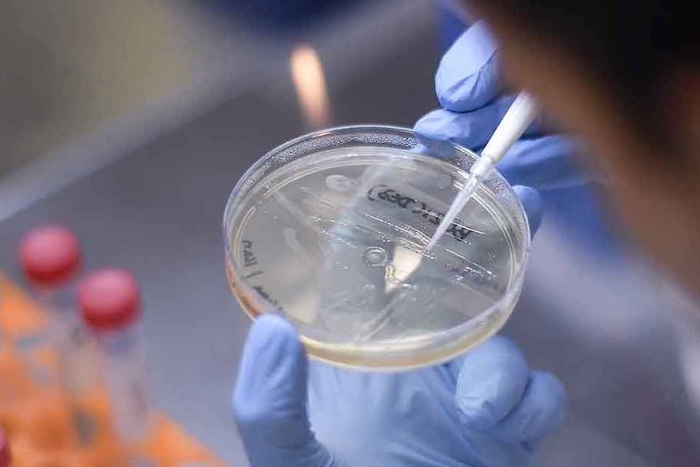

Hơn 140 ứng viên vaccine COVID-19 đang được WHO theo dõi, trong đó 3 vaccine đang trong giai đoạn thử nghiệm cuối cùng.
Theo Tổ chức Y tế Thế giới WHO, tính đến ngày 15.7, có 140 vaccine ở giai đoạn tiền lâm sàng, 19 vaccine trong giai đoạn thử nghiệm 1; 11 vaccine giai đoạn 2; và 3 vaccine trong giai đoạn thử nghiệm cuối cùng. Chưa có vaccine COVID-19 nào được chấp thuận.
Vaccine thông thường cần nhiều năm thử nghiệm và thời gian để sản xuất ở quy mô lớn, nhưng các nhà khoa học đang hy vọng phát triển vaccine COVID-19 trong vòng 12 đến 18 tháng.
Trong giai đoạn thử nghiệm tiền lâm sàng, các nhà nghiên cứu tiêm vaccine cho động vật để xem liệu nó có kích hoạt phản ứng miễn dịch hay không.
Trong giai đoạn 1 thử nghiệm lâm sàng, vaccine được tiêm cho một nhóm nhỏ người để xác định xem nó có an toàn không và để tìm hiểu thêm về phản ứng miễn dịch mà nó gây ra.
Trong giai đoạn 2, vaccine được tiêm cho hàng trăm người để các nhà khoa học có thể tìm hiểu thêm về sự an toàn và liều lượng chính xác của nó.
Trong giai đoạn 3, vaccine được tiêm cho hàng nghìn người để xác nhận sự an toàn của nó – bao gồm cả các tác dụng phụ hiếm gặp – và hiệu quả.
Công ty Sinovac của Trung Quốc đang phát triển một loại vaccine dựa trên các hạt COVID-19 bất hoạt. Vaccine đã cho thấy một hồ sơ an toàn đầy hứa hẹn trong các giai đoạn đầu thử nghiệm và hiện đang chuyển sang thử nghiệm giai đoạn 3 ở Brazil.
Vaccine COVID-19 của Đại học Oxford, Anh, được gọi là vaccine vector tái tổ hợp chứa mã di truyền của các gai protein được tìm thấy trên COVID-19 và kích hoạt phản ứng miễn dịch mạnh mẽ trong cơ thể con người.
Vaccine này đang trong thử nghiệm giai đoạn 2/3 ở Anh và gần đây đã đi vào thử nghiệm giai đoạn 3 ở Nam Phi và Brazil.
Ứng viên vaccine của công ty Trung Quốc CanSino Biologics và Viện Công nghệ sinh học Bắc Kinh cho thấy kết quả đầy hứa hẹn trong thử nghiệm giai đoạn 2, mặc dù không có dữ liệu nào từ thử nghiệm được công bố. Vaccine hiện đã được phê duyệt cho sử dụng quân sự, nhưng không rõ nó sẽ được phân phối rộng rãi như thế nào.
Vaccine mRNA-1273 do hãng dược Mỹ Moderna thử nghiệm đã tạo ra kháng thể trung hòa ở tất cả những tham gia thử nghiệm giai đoạn đầu – theo dữ liệu công bố tối 14.7 trên tạp chí y khoa New England Journal of Medicine.
Kháng thể trung hoà vốn được xem là quan trọng trong việc hình thành khả năng miễn dịch. Hôm 14.7, Moderna tuyên bố sẽ bắt đầu thử nghiệm giai đoạn cuối của vaccine ngừa COVID-19 từ 27.7 tới.
Viện nghiên cứu trẻ em Murdoch, Đại học Melbourne, Australia, đang tiến hành thử nghiệm giai đoạn 3 bằng cách sử dụng vaccine lao gần 100 năm tuổi. Vaccine này không được cho là bảo vệ trực tiếp chống lại COVID-19 nhưng có thể làm tăng phản ứng miễn dịch không đặc hiệu của cơ thể.


